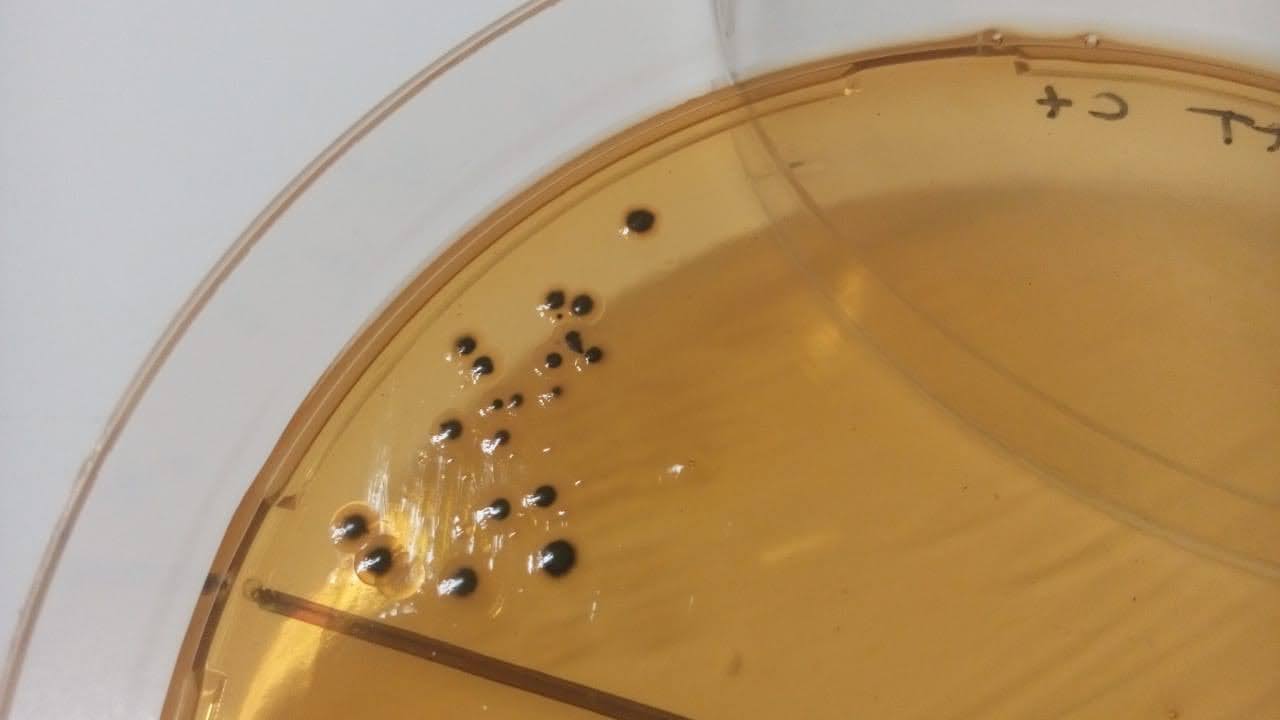

BLB Ingeniería Industrial
Somos un laboratorio de análisis de aguas y alimentos que inició sus actividades en la ciudad de Posadas, provincia de Misiones en el año 1.995, ofreciendo a los clientes asesoramiento técnico, análisis de control de calidad y control de procesos para sus productos.
Estamos abocados en brindar nuestros servicios con idoneidad, responsabilidad y absoluta confiabilidad a las industrias del sector alimentario de la región, que incluyen cooperativas, pequeñas y medianas empresas nacionales e internacionales.
Nuestros Servicios
Análisis microbiológicos:
Ofrecemos rapidez e idoneidad en la entrega de resultados microbiológicos, abarcando todos los indicadores de higiene y patógenos posibles que se encuentren en las muestras de alimentos o aguas.
Análisis fisicoquímicos:
Realizamos una amplia gama de determinaciones fisicoquímicas que brindan poderosas herramientas para caracterizar un alimento, controlar su calidad y adecuarse a las normas establecidas.
Análisis cromatográficos:
La cromatografía es una de las principales técnicas analíticas para la separación de distintas especies químicas en una mezcla y es capaz de proporcionar información cuantitativa sobre su composición. En BLB realizamos diversas determinaciones cromatográficas en diferentes tipos de alimentos.
Análisis de rotulado nutricional:
Ofrecemos confección de rotulado nutricional mediante el desarrollo de técnicas analíticas específicas para cada tipo de alimento, establecidas por el Código Alimentario Argentino.
Capacitación para empresas:
Diseñamos planes de formación y asesoramiento adaptados a las necesidades del cliente, enfocados en mejorar su competencia, desarrollados en el lugar de trabajo con capacitadores altamente capacitados.